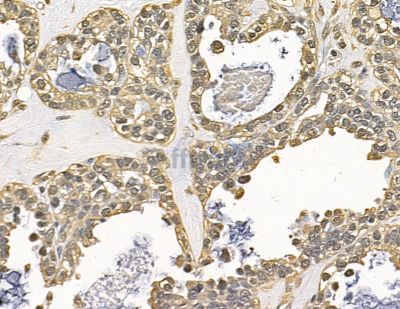
RNF8 Antibody - DF13868 at 1/100 staining human ovarian cancer by IHC-P.

RNF8 Antibody - #DF13868
Related Downloads
Protocols
Product Info
*The optimal dilutions should be determined by the end user. For optimal experimental results, antibody reuse is not recommended.
*Tips:
WB: For western blot detection of denatured protein samples. IHC: For immunohistochemical detection of paraffin sections (IHC-p) or frozen sections (IHC-f) of tissue samples. IF/ICC: For immunofluorescence detection of cell samples. ELISA(peptide): For ELISA detection of antigenic peptide.
Fold/Unfold
C3HC4 type zinc finger protein; E3 ubiquitin protein ligase RNF8; E3 ubiquitin-protein ligase RNF8; FLJ12013; KIAA0646; Ring finger protein (C3HC4 type) 8; RING finger protein 8; Ring finger protein 8, E3 ubiquitin protein ligase; RNF 8; RNF8; RNF8_HUMAN; UBC13/UEV interacting ring finger protein;
Immunogens
A synthesized peptide derived from Human RNF8.
Ubiquitous. In fetal tissues, highest expression in brain, thymus and liver. In adult tissues, highest levels in brain and testis, lowest levels in peripheral blood cells.
- O76064 RNF8_HUMAN:
- Protein BLAST With
- NCBI/
- ExPASy/
- Uniprot
MGEPGFFVTGDRAGGRSWCLRRVGMSAGWLLLEDGCEVTVGRGFGVTYQLVSKICPLMISRNHCVLKQNPEGQWTIMDNKSLNGVWLNRARLEPLRVYSIHQGDYIQLGVPLENKENAEYEYEVTEEDWETIYPCLSPKNDQMIEKNKELRTKRKFSLDELAGPGAEGPSNLKSKINKVSCESGQPVKSQGKGEVASTPSDNLDPKLTALEPSKTTGAPIYPGFPKVTEVHHEQKASNSSASQRSLQMFKVTMSRILRLKIQMQEKHEAVMNVKKQTQKGNSKKVVQMEQELQDLQSQLCAEQAQQQARVEQLEKTFQEEEQHLQGLEIAQGEKDLKQQLAQALQEHWALMEELNRSKKDFEAIIQAKNKELEQTKEEKEKMQAQKEEVLSHMNDVLENELQCIICSEYFIEAVTLNCAHSFCSYCINEWMKRKIECPICRKDIKSKTYSLVLDNCINKMVNNLSSEVKERRIVLIRERKAKRLF
Research Backgrounds
E3 ubiquitin-protein ligase that plays a key role in DNA damage signaling via 2 distinct roles: by mediating the 'Lys-63'-linked ubiquitination of histones H2A and H2AX and promoting the recruitment of DNA repair proteins at double-strand breaks (DSBs) sites, and by catalyzing 'Lys-48'-linked ubiquitination to remove target proteins from DNA damage sites. Following DNA DSBs, it is recruited to the sites of damage by ATM-phosphorylated MDC1 and catalyzes the 'Lys-63'-linked ubiquitination of histones H2A and H2AX, thereby promoting the formation of TP53BP1 and BRCA1 ionizing radiation-induced foci (IRIF). Also controls the recruitment of UIMC1-BRCC3 (RAP80-BRCC36) and PAXIP1/PTIP to DNA damage sites. Also recruited at DNA interstrand cross-links (ICLs) sites and catalyzes 'Lys-63'-linked ubiquitination of histones H2A and H2AX, leading to recruitment of FAAP20/C1orf86 and Fanconi anemia (FA) complex, followed by interstrand cross-link repair. H2A ubiquitination also mediates the ATM-dependent transcriptional silencing at regions flanking DSBs in cis, a mechanism to avoid collision between transcription and repair intermediates. Promotes the formation of 'Lys-63'-linked polyubiquitin chains via interactions with the specific ubiquitin-conjugating UBE2N/UBC13 and ubiquitinates non-histone substrates such as PCNA. Substrates that are polyubiquitinated at 'Lys-63' are usually not targeted for degradation. Also catalyzes the formation of 'Lys-48'-linked polyubiquitin chains via interaction with the ubiquitin-conjugating UBE2L6/UBCH8, leading to degradation of substrate proteins such as CHEK2, JMJD2A/KDM4A and KU80/XRCC5: it is still unclear how the preference toward 'Lys-48'- versus 'Lys-63'-linked ubiquitination is regulated but it could be due to RNF8 ability to interact with specific E2 specific ligases. For instance, interaction with phosphorylated HERC2 promotes the association between RNF8 and UBE2N/UBC13 and favors the specific formation of 'Lys-63'-linked ubiquitin chains. Promotes non-homologous end joining (NHEJ) by promoting the 'Lys-48'-linked ubiquitination and degradation the of KU80/XRCC5. Following DNA damage, mediates the ubiquitination and degradation of JMJD2A/KDM4A in collaboration with RNF168, leading to unmask H4K20me2 mark and promote the recruitment of TP53BP1 at DNA damage sites. Following DNA damage, mediates the ubiquitination and degradation of POLD4/p12, a subunit of DNA polymerase delta. In the absence of POLD4, DNA polymerase delta complex exhibits higher proofreading activity. In addition to its function in damage signaling, also plays a role in higher-order chromatin structure by mediating extensive chromatin decondensation. Involved in the activation of ATM by promoting histone H2B ubiquitination, which indirectly triggers histone H4 'Lys-16' acetylation (H4K16ac), establishing a chromatin environment that promotes efficient activation of ATM kinase. Required in the testis, where it plays a role in the replacement of histones during spermatogenesis. At uncapped telomeres, promotes the joining of deprotected chromosome ends by inducing H2A ubiquitination and TP53BP1 recruitment, suggesting that it may enhance cancer development by aggravating telomere-induced genome instability in case of telomeric crisis. Promotes the assembly of RAD51 at DNA DSBs in the absence of BRCA1 and TP53BP1 Also involved in class switch recombination in immune system, via its role in regulation of DSBs repair. May be required for proper exit from mitosis after spindle checkpoint activation and may regulate cytokinesis. May play a role in the regulation of RXRA-mediated transcriptional activity. Not involved in RXRA ubiquitination by UBE2E2.
Autoubiquitinated through 'Lys-48' and 'Lys-63' of ubiquitin. 'Lys-63' polyubiquitination is mediated by UBE2N. 'Lys-29'-type polyubiquitination is also observed, but it doesn't require its own functional RING-type zinc finger.
Nucleus. Cytoplasm. Midbody. Chromosome>Telomere.
Note: Recruited at uncapped telomeres (By similarity). Following DNA damage, such as double-strand breaks, recruited to the sites of damage (PubMed:18001824, PubMed:18077395, PubMed:22266820, PubMed:23233665). During prophase, concomitant with nuclear envelope breakdown, localizes throughout the cell, with a dotted pattern. In telophase, again in the nucleus and also with a discrete dotted pattern in the cytoplasm. In late telophase and during cytokinesis, localizes in the midbody of the tubulin bridge joining the daughter cells. Does not seem to be associated with condensed chromosomes at any time during the cell cycle. During spermatogenesis, sequestered in the cytoplasm by PIWIL1: RNF8 is released following ubiquitination and degradation of PIWIL1.
Ubiquitous. In fetal tissues, highest expression in brain, thymus and liver. In adult tissues, highest levels in brain and testis, lowest levels in peripheral blood cells.
The FHA domain specifically recognizes and binds ATM-phosphorylated MDC1 and 'Thr-4827' phosphorylated HERC2 (PubMed:18001824). This domain is required for proper recruitment to DNA damage sites after UV irradiation, ionizing radiation, or treatment with an alkylating agent (PubMed:23233665).
Belongs to the RNF8 family.
Restrictive clause
Affinity Biosciences tests all products strictly. Citations are provided as a resource for additional applications that have not been validated by Affinity Biosciences. Please choose the appropriate format for each application and consult Materials and Methods sections for additional details about the use of any product in these publications.
For Research Use Only.
Not for use in diagnostic or therapeutic procedures. Not for resale. Not for distribution without written consent. Affinity Biosciences will not be held responsible for patent infringement or other violations that may occur with the use of our products. Affinity Biosciences, Affinity Biosciences Logo and all other trademarks are the property of Affinity Biosciences LTD.